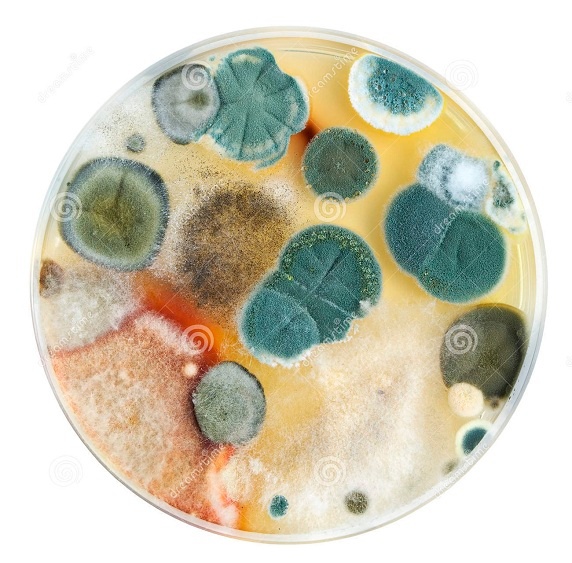

1. Kriminell-kommunistische Antifa
gegründet 1942 in Moskau unter Stalin gegen die
Wehrmacht - manipuliert die Rote Armee zum Massenmord an
Deutschen und zur Massenvergewaltigung an deutschen
Frauen
Die Antifa wurde 1942 in Moskau gegen die deutsche
Wehrmacht gegründet. Die Antifa ist eine
JÜDISCH-KOMMUNISTISCHE ORGANISATION, um ALLES zu
zerstören, was oder wer von der Antifa als "Feind"
definiert wird. Die Antifa ("Antifaschistisches Komitee"
mit dem lügenden jüdischen Schreihals Ehrenburg)

Ehrenburg ohne jede Ehre [2]
1) manipulierte die Rote Armee mit Flugblättern und
Zeitschriften pauschal gegen alle Deutschen, um alle
Deutschen zu töten, egal, von welcher Richtung sie waren,
und
2) die kriminelle Antifa manipulierte bzw. ermutigte die
Rote Armee immer wieder zur Massenvergewaltigung an allen
deutschen Frauen. Im Mai 1945 war die Arbeit der
kriminellen Antifa vorbei und der kriminelle
Kommunistenjuden-Hauptpropagandist Ehrenburg wurde von
Stalin ausrangiert. Die Rote Armee aber vergewaltigte
weiter die deutschen Frauen in der russischen Zone bis
1948, vor allem in Berlin, bis ein neues Thema kam.
2. Kriminelle Antifa ab 1949: wird vom
Mossad reaktiviert, um im Namen des kr. Zionisten
Rothschild und seinem kr. Mossad die GANZE WELT zu
manipulieren und infiltrieren
1948 liess Rothschild den Apartheid-Staat Israel
gründen, provozierte nebenbei die Vertreibung "Nakba" von
ca. 300.000 Palästinensern, die im Westjordanland und
Gazastreifen "konzentriert" wurden,

Nakba 1948 [3]
und 1949 installierte er seinen eigenen Geheimdienst
Mossad. Dieser Mossad hat die Antifa reaktiviert.
Die kriminelle Antifa kopiert nun auch
Strassenkampf-Methoden der Hitler-Jugend und der SA mit
Fahnenkult etc.




Hitler-Jugend mit Fahnenkult [7] - Kriminelle Antifa
mit Fahnenkult in Schwarz-Rot-Weiss [8] - Kriminelle
Hakenkreuzfahne in Schwarz-Rot-Weiss [9]
Man sieht klar: Die Antifa hat nicht nur den Fahnenkult -
sondern auch dieSELBE aggressive Farbkombination
Schwarz-Rot-Weiss übernommen.
Die kriminelle Antifa ist damit bewiesenermassen eine
Nazi-Organisation - alles als Feind definieren, ¨um viele
Leute hinter sich zu scharen, und alles zerstören.
Die Antifa-Frauen brillieren dann oft noch mit Minirock
und Kampfschuhen [41]
Das heisst im
Klartext: Die Antifa wird zu einer Nazi-Organisation,
nun einfach gegen die GANZE Welt mit
Strassenkampf, Bestechungen und Infiltration. Das
betrifft weltweit alle Regierungen, Institutionen, und vor
allem Justizapparate, um die 6-Millionen-Zahl und gewisse
Lager wie Auschwitz als "Vernichtungslager"
festzuschreiben, auch wenn die Fakten dagegensprechen.
Geschichtsforscher werden systematisch verfolgt und ihnen
die Existenz zerstört, sogar, wenn sie die Lösung für die
Zahlen der Judenverfolgung gefunden haben, und wenn sie
klar sagen, dass das Rote Kreuz ja nur eine Handvoll Lager
inspiziert hat, aber insgesamt bis 300 Lager existierten,
die vom Roten Kreuz gar nie kontrolliert wurden - dann
wird einfach nichts zur Kenntnis genommen und die
kriminelle Antifa in Regierungen und Justizsystemen
rufmordet einfach weiter, wie wenn nichts geschehen wäre,
denn Spionage sowie Rufmorde und Delikte erfinden ist doch
ein leichter Job mit viel Geld in der "westlichen" Justiz.
SO agiert der Rothschild gegen Aufklärer, in der Schweiz
seit 1993 seit der Einführung des "Antirassismusgesetz" -
das ist alles totaler Justizmissbrauch. Rehabilitation
findet bis heute (2024) KEINE statt. Fuck You Antifa!


Die Liste des Roten Kreuzes umfasst nur 13 von ca. 300
Lagern insgesamt [4]. Die kriminelle Antifa-Justiz will
aber KEINE RECHERCHE, sondern will die ewige Hetze gegen
die Wahrheitswisser, denn mit Lügen kann man gut Geld
scheffeln unter dem Schutz vom Roten Schild. Weitere
Zahlen-Wahrheiten über das Judentum sind hier (Webseite:
Zahlenrätsel gelöst 2020 -
Link).
Die kriminelle Antifa-Justiz kann oder will das NICHT
lesen - denn Rothschild in London will nicht lesen! [10]
Kriminelle Antifa mit Kalergiplan gegen Europa und
gegen die "USA": Die Schulung der "Flüchtlinge" und
Migranten zum Rauben und Vergewaltigen
Die kriminelle Antifa organisiert seit den Balkankriegen
seit den 1990er Jahren den Kalergiplan mit der Schleusung
von Millionen "Flüchtlingen" nach Europa, seit 2001 aus
Afrika, seit 2003 aus dem Irak und aus Afghanistan, und
seit 2014 aus Syrien etc., um Europa zu zerstören und in
einen Misch-Staat wie Brasilien umzuwandeln.

Kalergiplan von 1922: Europa mischen
und abstürzen lassen [5]
Die kriminelle Antifa ist wahrscheinlich auch in
Latein-"Amerika" aktiv, um 1000e Arme aus Latein-"Amerika"
in die "USA" zu leiten, die dort zum Teil
Bandenkriminalität und Mord und Todschlag an "Amerikanern"
verüben, manchmal auch die Haustiere klauen und fressen.
Es ist die kriminelle Antifa, die die "Flüchtlinge" schult
und instruiert, Adressbücher und Leitfäden an die
Flüchtlinge verteilt, wie sich "Flüchtlinge" in Europa
verhalten sollen. Es ist die kriminelle Antifa, die den
"Flüchtlingen" sagt, dass sie ihre Pässe vernichten
sollen. Es ist die kriminelle Antifa, die die
"Flüchtlinge" instruiert, weisse Frauen in Europa zu
vergewaltigen oder auch zu töten. Es ist die kriminelle
Antifa, die die Latinos in Latein-"Amerika" instruiert,
Frauen in den "USA" zu vergewaltigen oder auch zu töten.
Wir sehen, die kriminelle Antifa ist Weltmeister in Sachen
Anstiftung zu Mord und Vergewaltigung, bezahlt in
Deutschland z.B. vom "Bildungsetat", bezahlt in anderen
Ländern vielleicht vom zweitkriminellsten Juden der Welt:
Soros mit seinen destabilisierenden NGOs.

Krimineller ungarisch-jüdischer Billionär Soros 2020 in
Davos: will Europa und die "USA" mit allen Mitteln in
rassische Misch-Staaten verwandeln [6]
Sommer 2020: Black Lives Matter = Antifa
Unter Trump kurz vor den Wahlen im November 2020 bildete
die kriminelle Antifa eine neue Bewegung mit "Black Lives
Matter" mit denselben Symbolen, Verwüstung ganzer
Quartiere und Städte, was die meisten Schwarzen gar nicht
befürworteten (!). Das prinzipelle Problem, dass die
weisse Polizei in den "USA" oft viel zu früh mit Kugeln
schiesst, wurde damit aber nicht behoben, und das Problem
der kriminellen Antifa wurde erst recht nicht behoben. In
Oregon war "Black Lives Matter" besonders aktiv,
verwüstete die Hauptstadt Salem und istallierte dort ein
anarchisches Drogenzentrum (!). Das war gute Werbung für
die Demokraten mit der Halbleiche Biden, die mit einem
gigantischen Wahlbetrug mittels FAKE-Stimmenauszählung die
Wiederwahl von Trump verhinderten. So funktioniert
Antifa-Anarchie - und so was brauchen wir NIE!

Kriminelle Antifa = kriminelle Bewegung "Black Lives
Matter" [123]
1) hat 1942-1945 die Rote Armee instruiert, alle deutschen
Frauen zu vergewaltigen
2) manipuliert seit 2001 die Flüchtlinge aus muslimischen
Ländern wie Afghanistan, Irak und Syrien, weisse Frauen in
Europa zu vergewaltigen, und auch in Afrika werden die
Flüchtlinge in dieser Weise manipuliert oder an
Vergewaltigung gewöhnt
3) manipuliert seit 2001 auch die Latinos in
Latein-"Amerika", die "US"-Frauen zu vergewaltigen.
Wir sehen, diese kriminell-kommunistische Antifa stachelt
zu schlimmster Gewalt auf, sei es zur Tötung von Männern
oder Vergewaltigung von Frauen, immer wieder, DAS ist das
Rezept der Familie Rothschild, der kriminellsten und
reichsten jüdisch-zionistischen Familie auf der Welt mit
angeblich 500 Billionen Dollar Vermögen.
Und diese kriminelle Antifa LERNT NICHTS DAZU, sondern
wird vom Rothschild oder von jüdischen Regierungen in
Europa für ihre zerstörerischen und kriminellen Aktionen
gegen die eigenen Bevölkerungen noch hochbezahlt (!). Das
verdient nur einen Kommentar: Fuck You Antifa!
Die jüdischen Regierungen des "Westens" von Rothschild
klatschen zur kriminellen Antifa und zu Mord und
Vergewaltigungen durch "Flüchtlinge"
Und auch die jüdischen Regierungen in Europa wie Merkel
oder Macron etc. LERNEN NICHTS DAZU, weil das ein
jüdisches Kalkül ist, die Gesellschaft in Europa und in
den "USA" zu ZERSTÖREN, damit die Zionisten mit einem
Gross-Israel vom Nil bis zum Euphrat die Weltherrschaft
übernehmen (so hat sich die Welt im Komitee der 300 mit
dem Satz aus dem 1. Buch Fantasie-Mose, Fantasie-Kapitel
15, Fantasie-Satz 18 arrangiert).

Nazisrael im Jahr 2024 feiert bereits ein Imperium vom
Nil bis zum Euphrat an den Soldatenuniformen - die
Weltherrschaft mit Infiltration+Schmiergeldern reicht
noch nicht! [12]
Die Jüdin Merkel liess Millionen muslimische "Flüchtlinge"
nach Deutschland - und Obama und Biden machten dasselbe an
der Mexikanischen Grenze mit Latinos: reinlassen und die
Gesellschaft in den "USA" zerstören lassen. Ihr Ziel ist
die Anarchie, das KAOS und das INFERNO. Das sprayen die
Antifas seit Jahren immer wieder an Hausfassaden und an
Brücken.

Kriminelle Antifa verherrlicht das KAOS und das INFERNO,
Sammelfoto von einem Haus in Basel am 6.8.2022
[11]
Die kriminell-kommunistische Antifa zerstört ganze
Schulsysteme, spaltet Familien und treibt haufenweise
Trans-Jugendliche in den Selbstmord
Die Trans-Täter der "USA" - ich
vermute, Obama und Biden sind beide Mitglied der
kriminellen Antifa, um bewährte Staatsstrukturen zu
vernichten:




Obama fördert Trans (Obama Trans promoter) 2007-2015
[13] - Trump lässt ab 2018 LGBT im Schulsystem zu (Trump
LGBT promoter in school systems 2018) [14]
Biden lässt die LGBT-Doktrin in Schulen weiterlaufen,
Selbstmordrate bei der Trans-Jugend wegen
Unverträglichkeit der Gegenhormone: 41% [15]
Kriminelle Antifa in Therwil (Schweiz) 2022 mit schwerer
Sachbeschädigung durch Sprayen: Das "A" im Kreis mit der
Gender-Doktrin [50]
Zuerst ab Obama wurde die Trans-Propaganda neben
Lesben, Gays und Bi-Menschen hochgefahren - also wurde dem
LGB das "T" angehängt, das passierte zwischen 2004 und
2006, Obama ab 2007 belebte das "T" mit seinem Ladyboy
Michael Obama. Ab 2013 meinte Obama, nun sollte man auch
Propaganda gegen die Familie machen. Ab sofort wurde die
Definition von Mann und Frau in Frage gestellt. Ab 2018
mit Präsident Trump wurde in den "USA" die Doktrin von
LGBT auch ins Schulsystem integriert, um die Jugend zu
zerstören bzw. um viele Jugendliche wie möglich als neue
Dauerkunden der Pharma zu rekrutieren. Ausführende Kraft
ist die kriminelle Antifa, die die Schulsysteme
infiltriert und die Jugend mit LGBT in die Irre führt. Und
bei den Wahlen von 2020 wurden die "USA" mit FAKE-Videos
über die Halbleiche Biden wiederum in die Irre geführt,
wobei die FAKE-Videos über den "starken Biden" wieder von
Antifa-Agenten aus den Antifa-Medien stammten. Ich nehme
an, Obama und Biden sind beide selber Antifa, und die
LGBT-Doktrin im Schulsystem der "USA" provoziert seither
bei Trans-Jugendlichen die Selbstmordrate von 41% bzw. 19x
höher als "normal" wegen der Unverträglichkeit der
Gegenhormone.
Gewisse EU-Staaten kopieren diese kriminellen
LGBT-Aktivitäten in Schulsystemen - die kriminelle Antifa
tut es ohne nachzudenken. All diese LGBT-Aktivitäten
werden von London von der Familie Rothschild gesteuert, um
die "USA" und Europa zu zerstören mit der Begründung, die
Menschen in den "USA" und in Europa seien "zu gescheit",
man müsse ihren IQ mit der Zerstörung der Gesellschaft
senken, zuerst mit Flüchtlingen - und nun auch mit der
zerstörerischen LGBT-Propaganda, um die Familien
auseinanderzureissen und mit neuen Dauerproblemen zu
behaften. Manche fügen noch ein "Q+" für "quer" hinzu.
LGBT in Schulsystemen ist totaler Missbrauch und
Irreführung der Kinder und Jugendlichen, denn Identität
ist PRIVATSACHE - aus und fertig. Und die kriminelle
Pharma soll sich endlich zupfen vom Planet, 90% der
Pharma-Produkte sind überflüssig, das ist bewiesen, und
die Naturmedizin kann mit Mutter Erde die meisten
Krankheiten heilen OHNE Pharma. Da gibt es ja nicht nur
das Natron, die Blutgruppenernährung, das
Eierschalenpulver oder das Silberwasser etc. - siehe z.B.
die Webseite
www.med-etc.com
WAS macht die kriminelle Antifa in den Schulen mit dem
LGBT-Programm? Die kriminellen und ungebildeten
Gruppenführer der Antifa (das sind teilweise sogar quasi
Analphabeten ohne Schulabschluss, die nur spionieren und
Delikte erfinden können) erzählen Lügen herum, dass Kinder
"im falschen Körper" geboren seien. Und dann dürfen sich
die 13 Jahre alten Jugendlichen, bei denen die Sexualität
erst gerade begonnen hat, eine Identität "aussuchen". Das
ist erst der Anfang der Lügen und Irreführung, denn wenn
sich die Jugendlichen "Trans" aussuchen mit der
Behauptung, sie fühlten sich "wohler" mit dem jeweils
anderen Geschlecht, dann labert der Antifa-Gruppenleiter
folgendes:
-- sie verharmlosen dann die Pubertätsblocker und die
Gegenhormone, und sie verharmlosen die
Geschlechtsoperationen: das sei ein "Trip" oder als Reise"
("journey") - und die 13 Jahre alten Jugendlichen erkennen
die Falle NICHT, weil das ganze Manöver in den Schulen
stattfindet und die Lehrpersonen sich ebenfalls von der
kriminellen Antifa manipulieren lassen und die Falle AUCH
NICHT ERKENNEN
-- scheinbar haben die kriminellen Antifa-Gruppenführer
mit diesen Verharmlosung von Pubertätsblockern,
Gegenhormonen und Geschlechtsoperationen die Aufgabe, so
viele Jugendliche wie möglich zu manipulieren und so den
Chirurgen für die Trans-Operationen die Taschen zu füllen,
denn das Krankenkassensystem ist so manipuliert worden,
1) dass in den "USA" die Geschlechtsoperationen an
Jugendlichen bis 18 gratis sind
2) dass die Chirurgen mit den Geschlechtsoperationen an
Jugendlichen Millionen verdienen.
Die fanatisch manipulierten Trans-Jugendlichen erkennen
die Falle nicht, weil das ganze Manipulationssystem im
Schulsystem installiert ist und das Vertrauen missbraucht
- und bezeichnen das einfach als "Trip" oder "Reise". Die
fanatischen Trans-Jugendlichen glauben die Warnungen
nicht,
und
-- die Antifa verheimlicht die Wahrheit EBENFALLS:
1) über die geistige Retardierung durch Pubertätsblocker,
2) über die Schmerzen durch die Gegenhormone, oder über
die Krankheiten durch Gegenhormone und die
Selbstmordrate
von 41%, wenn Trans-Jugendliche durch ihre
Schmerzen und Krankheiten die Schule nicht mehr schaffen.
Da sind KEINE Warnungen, KEINE Zahlen, KEINE Fakten (!).
Die LGBTQ-Mafia besteht aus:
Antifa+Pharma mit den
Pubertätsblockern, den Gegenhormonen und den Chirurgen.
Sie sind die Haupttäter, die die Jugend mit Manipulationen
missbrauchen, und da sind auch Erpressungen (also
Warnungen gibt es keine, aber die Antifa-Gruppenleiter
befehlen dann: mach dies, mach das, mach das - du musst
dir die Haare abschneiden - du musst auf eine Toilette für
Männer gehen - und Operationen sind nur bis 18 gratis).
Das ist alles ILLEGAL+KRIMINELLE NÖTIGUNG+ERPRESSUNG -
organisiert von der kriminellen Antifa!
4. Was zu erwarten war: Kriminelle Antifa
mit "Corona"-Wahn 2020-2023 - und die Selbstvernichtung
mit "Coronaimpfungen"
Die grausame Antifa-Tradition, immer "Nazis" zu erfinden,
wurde nun auf die UNgeimpften angewandt:




Coronawahn mit "Spikes", Grafik [16] - Antifa-Demo in
Bielefeld (Deutscheland) mit dem Schild "Nazis töten"
[17]
Hochkriminelle Antifa mit Graffito: UNgeimpfte ins Gas -
14.8.2021 [119]
Demo gegen Corona-Terror in Köln gegen Maskenzwang: Nur
wer eine Maske hat, ist frei - Vergleich mit der
Stigmatisierung des Judentums 1933-1945 - der
Maskenzwang verletzt die Grundrechte im Grundgesetz -
Leute mit Maske haben ihr Gehirn abgeschaltet: "Maske an
- Gehirn aus" [18]



Kriminelle Impfpropaganda im 4R mit Uschi Glas: "Ärmel
hoch" 2021 [prop 01] - Impfpropaganda in Basel bei der
BVB mit einem "Coronatram" 2022 [prop 02]
Kriminelle Impfpropaganda in der Schweiz mit Anne Levy:
"Schützen - testen - impfen" - 2021 [prop 03]


Kriminelle Impfpropaganda Schweiz: Die erste Person mit
"Coronaimpfung" ist eine 90 Jahre alte Frau - 23.12.2020
[prop 04] -
Kriminelle Impfpropaganda in Bayern (4R): Herr Söder
macht 7mal seine Impfshow mit FAKE-Impfungen [prop 05]
Dieselbe kriminelle Antifa, die schon die Schulsysteme des
"Westens" mit dem kriminellen Trans-Wahn und "Safe Zone"
manipulierte, wurde vom jüdisch-zionistischen Oberboss
Rothschild nun auch für die Propaganda zur "Coronaimpfung"
eingesetzt. Dabei sind die "westlichen" Medien von
Rothschild schon seit 2010 ca. fast zu 100% von der
kriminellen Antifa infiltriert:
-- JournalistInnen sind Antifa-Leute
-- Chefredaktoren sind Antifa-Leute
-- Fernsehmoderatoren sind Antifa-Leute
und zufällig oft noch jüdische oder christliche ZIONISTEN.
Sie unterstützten die jüdischen Regierungen wie Merkel
BEDINGUNGSLOS, und zuerst kamen dann die Masken-Skandale
(in Deutschland mit Herrn Spahn), dann die
Impfstoffskandale (in Deutschland mit Lauterbach). Aber
die Propaganda der Antifa gegen die Wahrheitswisser blieb
bis 2023 gleich, sie erfanden immer "Nazis und
Rechtsradikale"...
Das Judentum ist in den Medien des "Westens" hoffnungslos
überrepräsentiert, und da sie nicht auffliegen wollen,
dürfen sie KEINE Skandale provozieren und müssen den
Befehlen des Oberboss Rothschild aus London immer
GEHORCHEN, sonst sind sie bald KEINE JournalistInnen mehr.
Um diesen Zwang von Rothschild zu erfüllen, nach seinem
Befehl zu schreiben, müssen die JournalistInnen lügen,
lügen, lügen, Jonas Dreyfus in Basel ist nur einer von
vielen, der mit seinen Zeitungsartikeln in der Schweiz
"schöne Propaganda" für die "Coronaimpfung" machte, wohl
nicht ohne Schmiergeld von der Basler Pharma. An die
Lügerei sind sich die AntifantInnen ja seit 1949 gewohnt -
schon dort wurde der Völkermord an den Palästinensern
geleugnet, und seit 1949 wird Apartheid-Israel immer als
"gut" dargestellt. Und: seit 1949 muss auch Russland immer
als "böse" dargestellt werden, was nur zwischen
Gorbatschow 1986 und dem Maidan von Kiew 2014 nicht so
war. Bei den "westlichen Medien" ist es im Jahre 2020
klar: Antifa-Mitgliedschaft ist PFLICHT und wer nicht
mitlügt, fliegt. Die Teilnahme an absolut sinnlosen
Demonstrationen "Basel nazifrei" oder "Zürich nazifrei"
mit Blockade des ÖV ist Pflicht, auch wenn der Begriff
"Nazi" gar nicht richtig definiert wurde.
Der Maskenwahn - provoziert durch die
Masken-Hetze der kriminellen Antifa 2020-2021




Masken 01: GB-Busfahrer OHNE Maske transportiert
"Coronakranke" mit Maske - 4.2.2020 [masken 01] -
China: Kinder müssen mit Maske Sport machen, 2 fallen
tot um - Meldung vom 14.5.2020 [masken 02] -
Maskenwahn 03: provoziert Dauer-Akne und Narben in
Gesichtern ohne Ende - 19.3.2021 [masken 03] -
Maskenwahn 04: provoziert Dauer-Akne - 2022 [masken 04]




Maskenwahn 05: Plexiglasrohr im 4R irgendwo [masken 05]
- Maskenwahn 06: im Gym mit Kabinen (wahrsch. "USA")
[masken 06]
Maskenwahn 07: Die Mossad-Propaganda will noch mehr
Masken verkaufen+behauptet, man solle ZWEI Masken tragen
- als BH vielleicht - 16.2.2021 [masken 07]
Maskenwahn 08: Das Kantonsspital Basel gab am 25.7.2021
zu: "Die Impfung schützt nicht vor Ansteckung" und man
müsse also weiter Masken tragen (!) - 25.7.2021 [masken
08]



Warnung 16.5.2022: Masken sind wie eine Petrischale
[masken 09] - 30.5.2022: Masken sind wie eine
Petrischale - die Realität unter dem Mikroskop [masken
10]
Maskenwahn in China gegen Kinder: gesteigert mit
Ganzkörperanzug - 21.7.2021 [masken 11]



Die kriminelle Antifa wurde ab 2023 hyperaktiv, um ihre
Impfschäden zu vertuschen, z.B. mit dem Kleber "Basel
bleibt nazifrei" 2023 [19]
Kriminelle Antifa in Basel mit dem Transparent "Basel
nazifrei" mit der kommunistischen Antifa-Faust [20]
Kriminelle Antifa in Basel blockiert jeden ÖV an Demo
2020 mit RJB-Fahnen (Revolutionäre Jugend Basel) - also
Fahnenkult wie die Hitler-Jugend [21]
Also wird nun klar: Die Antifas sind die Nazis.





Kleber der kriminellen Antifa in Basel: Esst Nazis! -
Feb.2024 ca. [40] - Scheinbar ist die Antifa auch in den
Tunnelsystemen mit Kannibalismus angekommen.
Kriminelle Antifa-Frauen im Minirock mit Schlägerschuhen
/ Kampfschuhen 02 [42] - Verlorene kriminelle
Antifa-Frauen im Rock mit Schlägerschuhen, Basel
9.8.2022 [43]
Sie sind verloren, denn sie glauben den falschen
Anweisungen der Antifa-Führung, den falschen
Feindbildern, lassen sich verhetzen+leben am Planeten
vorbei.
Die kriminelle Antifa mit dem Nazi-Fahnenkult in
Schwarz-Rot-Weiss in Luzern im November 2022 [44] - und
in Aarau im November 2022 [45]



Die kriminelle Antifa zelebriert ihre "Kultur" mit
Saufen in Basel z.B. mit dem Kleber "Dr Völlscht isch dr
töllscht" [48]
Kriminelle Antifa in Therwil mit schwerer
Sachbeschädigung durch Sprayen: Hetze gegen alle Sparer
"Krieg dem Kapital A" [49]
Kriminelle Antifa in Therwil 2022 mit schwerer
Sachbeschädigung durch Sprayen: Das "A" im Kreis mit der
Gender-Doktrin: 2 Pfeile aufwärts+1 Kreuz nach unten
[50]



Die kriminelle Antifa manipuliert die Jugendlichen, sie
seien "revolutionär", wenn sie bei der "Antifa" seien:
Abkürzung RJB=Revolutionäre Jugend Basel - aber die
lernen dort nur kriminelle Sachen wie lügen, zerstören,
Rufmorde betreiben, spionieren etc. [51]
Jede Region der Schweiz bekommt ihren Buchstaben, also
RJZ=Revolutionäre Jugend Zürich [52] - totaler
politischer Missbrauch der Jugend durch Rothschild, denn
man lernt bei der Antifa einfach GAR NICHTS ausser
herumschreien, Sachen erfinden, lügen, Sachen
beschädigen, Leute in Gefahr bringen und töten (!)
wobei die kriminelle Antifa meistens warnt, wer sie ist:
Hammer und Sichel=Kommunismus mit Kolchosen und
Gruppenzwang-Sklaverei von Geburt bis Tod und Besitz ist
verboten.
Kriminelle Antifa-Jugendliche lernen bei der Antifa
lügen, zerstören, Rufmorde betreiben, spionieren,
Strassensex+Saufen, mehr nicht - hier ist einer in
Küsnacht (ZH) [53] - das nennt sich "Jugendarbeit"
angeleitet vom Mossad von Rothschild, um die
Gesellschaft in Europa hirnlos zu machen und zu
zerstören...
Und die Mossad-Medien warnen nicht, sondern lassen die
Jugend von ganz Europa bei der kriminellen Antifa ins
Messer laufen: Sie meinen, sie seien "revolutionär",
wenn sie NICHTS LERNEN, sondern nur hetzen+saufen...
Die kriminelle Antifa wurde also ab 2023 hyperaktiv vor
Verdrängung der Wahrheit über die tödliche
"Coronaimpfung", fanatisch - eben Wahn ohne Datengrundlage
- und Selbstmord durch "Coronaimpfung" - kombiniert mit
Strassensex im Park, schlechter Ernährung und viel Alkohol
- und sie sprayen laufend ihren Scheiss an Hausfassade,
Brücken und an Zugwagen, hohen Sachschaden provozierend.
DAS ist, was die Antifa für Jugendliche wirklich ist - ein
totales DESASTER. Das Ziel dabei ist die Jugend zu
verdummen und ein neues Proletariat für eine neue
Kommunistische Partei heranzuzüchten. Aber sie sind ja
alle geimpft...
Die kriminelle Antifa in Deutschland prahlte mit
"Corona"-Parolen auf Plakaten und Transparenten, um die
UNgeimpften als "Nazis" zu rufmorden:
-- "Maske auf - Nazis raus", Demo 22.1.2022 in Düsseldorf
[web01], auch in Berlin am 9.8.2020 [web05]




Berlin: Demo für Coronaterror mit Transparent: Masken auf
- Nazis raus" - 9.8.2020 [22]
Kriminelle Antifa in Schaffhausen macht
"Corona"-Impfwerbung mit Impfung und Spritze in einem
Kinderluftballon - die totale Irreführung ohne
Weiterbildung - 2021 [62]
Kriminelle Antifa Basel hetzt gegen Ueli Maurer wegen
einem T-Shirt - 27.11.2021 [69] - Freiheitstrychler gegen
die kr. Impf-WHO in Genf - 3.6.2023 [127]
Also man sieht, die kriminelle Antifa ist "impfsüchtig"
und missbraucht dabei sogar Kinderspielzeuge wie
Luftballons, um für die tödliche "Coronaimpfung" zu
werben. Hier sind ein paar Sprüche der medizinisch
bildungslosen Antifa an Demonstrationen in Deutscheland:
-- "Impfen - dein Beitrag für die Gesellschaft", Demo
22.1.2022 in Düsseldorf [web02]
-- "Impfen rettet Leben" - "Impfen statt schimpfen", Demo
22.1.2022 in Düsseldorf [web03]
-- die kr. Antifa war STOLZ auf die tödliche
"Coronaimpfung": "Pandemie und trotzdem da - durchgeimpfte
Antifa" - Demo in Trier 20.1.2021 [web04]

Und auf diese Art und Weise haben die kriminellen
Antifa-Medien die Massen zur "Coronaimpfung" manipuliert,
immer mit der Rufmorderei, UNgeimpfte sollten "Nazis"
sein, so haben sie mit Lügen Angst geschürt, auch am
Arbeitsplatz, haben ihre Propagandafeste gefeiert, wo sie
ihre Lügen auf den Bühnen präsentierten, haben die
Wahrheitswisser systematisch und immer wieder als "Nazis
und Rechtsradikale" gerufmordet (inklusive
Regierungsmitglieder, z.B. ein Herr Berset in der Schweiz,
der mit einer Ausbildung in Handel OHNE jede Ausbildung in
Medizin oder Naturmedizin den schweizer
"Gesundheitsminister" spielte - und eine Managerin Frau
Levy hetzte als Managerin des Gesundheitsamts BAG OHNE
jede Ausbildung in Medizin oder Naturmedizin die ganze
Schweiz zum "impfen impfen impfen" für ihre Pharma-Aktien,
oder in Deutscheland ein Herr Spahn, der ein Bankkaufmann
ist, mehr ist er nicht...).
"Elite": FAKE-Gesundheitsminister
Berset in der Schweiz ohne Medizinausbildung - er hat
Wirtschaft studiert (Aktien!) [34]
"Elite": FAKE-Gesundheitschefin des BAG Schweiz Frau
Levy ohne jede Medizinausbildung - sie ist Managerin mit
Basler Pharma-Connections (Aktienhandel!) [32]
"Elite": FAKE-Gesundheitsminister Spahn in Deutscheland
ohne Medizinausbidlung - er ist Bankkaufmann
(Aktienhandel!) [33]


Die FAKE-Gesundheitsminister Berset+Levy bestellen am
22.6.2022 33 Millionen neue "Coronaimpfungen" - Code 33,
der höchste Code der kriminellen Freimaurerei [taeter
06]
Impfwerbung: Die BVB in Basel feiert ein "Coronatram"
2022 [prop02]



Täter 01: Die "Corona"-Verbrecher im 4R, Sammelfoto -
23.1.2022 [taeter 01] - Täter Lauterbach (4R): Er
behauptete, Omikron sei für UNgeimpfte lebensgefährlich
- 2.1.2022 [taeter 02] - Täter 03: Spahn rechnete mit
einer Impfpflicht, so dass die Pharma-Börsenkurse weiter
steigen würden, Profit für ihn ohne Arbeit [taeter 03]



Täter 04: Für Frau Anne Levy ist die Hetze gegen
UNgeimpfte KEIN Problem - und vor allem lernt sie NICHTS
dazu! [taeter 04] -
Täter 05: Täterin Levy (die schweizer Impf-Hexe) trieb
die Massen zur "Coronaimpfung", damit ihre Pharma-Aktien
stiegen - und liess im BAG ALLES zensieren, was der
"Corona"-Wahrheit zu nahe kam - Delikt: Irreführung an
der GANZEN SCHWEIZ [taeter05]
Täter 06: Täter Berset+Levy bestellen 33 Millionen neue
"Coronaimpfungen" - Code 33 höchster Freimaurer-Code -
2.6.2022 [taeter06]



Täter 07: Der tödliche "Corona"-Impfbus (GENimpfbus)
steht in Basel am Barfüsserplatz - 20.9.2021 [taeter 07]
Täter 08: Berset mit Pinocchio-Nase, er hat zu viel
gelogen - 27.4.2023 [taeter 08]
Täter 09: Lauterbach (4R) hetzt in einer Rede gegen
UNgeimpftes Personal und zeigt einen Hitlergruss -
23.6.2023 [taeter 09]



Täter 10: Lauterbach (4R) muss im Bundestag zugeben,
dass die "Coronaimpfungen" doch nicht so gut vor
Infektionen schützen - 11.7.2022 [taeter 10]
Die Mossad-BILD machte immer Impfwerbung: Zuerst sollte
die "Coronaimpfung" ein Leben lang schützen, dann immer
weniger, am Ende sollte man alle 6 Monate impfen
(Scholz) - aber ganz am Ende alle DREI Monate (es geht
nur um Börsenkurse!) - 13.1.2022 [taeter 11]
Merkel hat mit dem Corona-Ermächtigungsgesetz die GANZE
MACHT gegen die GANZE Bevölkerung, immer mit dem Vorwand
"Grippe" - 6.11.2020 [taeter 12]



"Coronapanik" in Griechenland provozieren geht so: Wenn
Familien einverstanden sind, "Corona" als Todesursache
in den Totenschein zu schreiben, bekommen sie 400 Euro
Schmiergeld - 9.9.2020 [taeter 13] -
Täter 14: Die Managerin Anne Levy (Schweiz), Chefin des
BAG, hat KEIN Verständnis für UNgeimpfte (denn ohne
Impfungen steigen keine Börsenkurse!) - 12.12.2021
[taeter 14]
Täter 15: Kuchenbäckerin Von der Leyen in Grüssel (die
Chefin der EU) versteckt weiterhin ihren Pfizer-Deal mit
SMS mit dem Pfizer-Boss Bourla 20.4.2024 [taeter 15]
Schlussfolgerungen:
Man kann gut annehmen, dass die TäterInnen auch alle bei
der Antifa sind - und dass die Antifa-Führer vom Mossad
ebenfalls Pharma-Aktien haben.
In Deutscheland wurde der Slogan "Impfen statt schimpfen"
millionenfach wiederholt gezeigt und dann bei der
Jesus-Fantasie-Kirche die "Solidarität" durch Impfung
beschworen. Das ging aber nur, weil die kriminelle Antifa
zuerst die UNgeimpften alle als "Nazis" tituliert hatte -
bis heute (2024) straffrei. WO ist der Prozess gegen diese
kriminelle Antifa? Wo ist der Prozess gegen die
FAKE-Gesundheitsminister? Man kann ruhig annehmen, dass
die FAKE-Gesundheitsminister auch Mitglied bei der Antifa
sind. Sie stellten dann auch Impfbusse und Impftrams auf,
um das Impfgift in "gewohnter Umgebung" abzugeben. In
England konnte man "den Schuss" auch in
Jesus-Fantasie-Kathedralen empfangen...



Merseburg (Deutscheland) Antifa-Demo für Impfzwang im 4R
am 2022: "Impfen statt schimpfen" [23]
Die Steigerung: Berlin-Spandau: Die kr.
Jesus-Fantasie-Kirche propagierte die tödliche
"Coronaimpfung" mit der Lüge: "Impfen ist Nächstenliebe"
[24]
4R München Impftram für die "Coronaimpfung", und daneben
stehen gleich mehrere Krankenwagen für die, die an der
"Coronaimpfung" sofort sterben [28]

London: Die heilige, tödliche "Coronaimpfung" konnte man
auch in der Westminster-Kathedrale erhalten, begleitet
von einem Fantasie-Jesus - 10.3.2021 [115]
Noch ein Fakt: Die Warteschlange für die erste
"Coronaimpfung" in Basel Anfang 2021 ging vom
Kantonsspital bis zur Universität am Petersplatz (die
Warteschlange war am Samstags-Flohmarkt auf dem
Petersplatz jeweils gut sichtbar). Noch ein Fakt:
Natürlich sind alle Antifas geimpft (Spruch in der
schweizer Antifa: Nid schimpfe - impfe!). Die kriminelle
Antifa in der Schweiz liess sich NICHT vor der
"Coronaimpfung" warnen, sie hetzten sich in Rage "gegen
Nazis", alle, die nicht Antifa waren, sollten "Nazis"
sein, die Antifa mit ihrer kommunistisch-jüdischen Führung
an der Leimenstrasse 24 in Basel war im
selbstzerstörerischen WAHN

Zion-Synagoge in Basel Leimenstrasse 24 in 4055 Basel,
das Zentrum, von wo aus die schweizer Politik seit 1993
mit der Antifa+akdh CH manipuliert wird, nicht nur mit
Frau Levy dort drin, sondern auch mit Dr. Eymann, Eva
Eichenberger, Samuel Althof, und niemand von denen hat
irgendeine medizinische Ausbildung [39]
und heute (2024) sind manche schon nicht mehr da bzw.
haben schwere Impfschäden im Rollstuhl oder leben an
Krücken oder können nicht mehr raus vor Müdigkeit oder
wegen zu sensibler Augen etc. Die Gift-Pharma nennt den
"Corona"-Impfschaden auch "PostVac-Syndrom", um das Wort
"Impfschaden" zu vermeiden...
Mit dem "Coronawahn" hat der Rothschild seine Antifa also
in die "letzte Schlacht" gegen die Wahrheitswisser
geschickt, und mit der "Coronaimpfung" in den Selbstmord.
Sie werden WENIGER, ganz vorbei ist die kriminelle Antifa
aber leider noch nicht.
"Corona"-Impfopfer, die der Mossad und die
Antifa verschweigen (Berset, Levy, Spahn, Lauterbach
etc.)
Die Wahrheitswisser waren ca. alle 6 Monate mit grossen
Demos unterwegs, um auf die tödliche "Coronawahrheit"
aufmerksam zu machen. Hier sind Beispiele von Amputierten
und von Leuten, die im Sommer bei 25 Grad kalt haben und
Winterkleidung tragen:


Verdacht "Corona"-Impfschaden in Pharma-Basel im
August 2022: Frau mit amputiertem Unterarm und mit
amputiertem Bein im Rollstuhl [25]
Verdacht "Corona"-Impfschaden in Basel: 3x
Winterkleider bei 25 Grad am 20.8.2022 [26]
Statistiken: Übersterblichkeit und Anstieg schwerer
Krankheiten ab der "Coronaimpfung" ab Anfang 2021

Klare Zahlen "USA": 2020 war eine Untersterblichkeit,
und ab der "Coronaimpfung" herrscht Übersterblichkeit
Grafik 2021 und 2022 [27]




Übersterblichkeit Statistik Todesrate: Die
"Coronaimpfung" provoziert 4520% MEHR TOTE als die
"Coronagrippe" [78] -
Statistik: 2020 waren die Spitäler LEER, ab der
"Coronaimpfung" 2021 aber bumsvoll [79]
Statistik Österreich "Coronapatienten" in der
Intensivstation: Die "Coronaimpfung" provoziert MEHR
"Corona" [80]
Statistik eines Bestatters im 4R: Seit der
"Coronaimpfung" 3x mehr Tote bei Leuten ab 60 [81]



Statistik Deutscheland: Die "Coronaimpfung" ist in
Deutscheland schon am 26.8.2021 die tödlichste Impfung
aller Zeiten [116]
Statistik 4R: Die "Coronaimpfung" provoziert 2021 so
viele Krankschreibungen wie nie eine Impfung zuvor -
Steigerung um das 213-Fache [117]
Statistik "USA" am 24.7.2022: Die "Coronaimpfung"
provoziert schwere Krankheiten wie noch NIE eine
Impfung zuvor:
Thrombosen - Lungenembolien - Schlaganfälle und
Fehlgeburten [118]
Grauenhafte Nebenwirkungen (Hauptwirkungen!) der
tödlichen "Coronaimpfungen" - Beispiele (1/3 der
Chargen waren Plazebo, um die Welt zu verwirren)




Statistik "USA" Herzmuskelentzündungen
bei Kindern: 2019 und 2020 je 4, ab der
"Coronaimpfung" im Jahr 2021 waren es 2236 Fälle [54]
"Corona"-Impfschaden: Sammelfoto mit Hautausschlag und
schwarzen Zehen [55]
Verdacht "Corona"-Impfschaden: Ein Wachsoldat ist
umgefallen - 4.Juni 2022 [56]
"Corona"-Impfschaden 13.5.2022 mit
Leukozytoklastischer Vaskulitis (Venenentzündung) nach
der 3. "Coronaimpfung" [57]




"Corona"-Impfschaden in China: Die ganze Haut pellt
sich ab - 2022 [58] - "Corona"-Impfschaden: immer
wieder Faserblutgerinnsel - 2022 [59]
"Corona"-Impfschaden: immer wieder Halbseitenlähmung /
Gesichtslähmung - Witz: Das ist das neue
"Pfizer-Lächeln" [60]
"Corona"-Impfschaden in Marokko: Am Impfarm faulen
alle Finger weg [61]



"Corona"-Impfschaden: Blutgerinnsel und Entzündung
herausoperiert [63] - "Corona"-Impfschaden:
Blutschaden mit zerstörten Blutkörperchen [64]
"Corona"-Impfschaden: UNgeimpftes Blut rot - geimpftes
Blut braunrot - 2021 [65] - und Berset, Levy, Spahn
und Lauterbach wollen das bis heute NICHT lernen
(2024)!



"Corona"-Impfschaden "USA": Nach der "Coronaimpfung"
faulen Arme und Beine weg [66] - "Corona"-Impfschaden:
Nach einer Thrombose Beinverlust [67]
"Corona"-Impfschaden Thailand: Nach der
"Coronaimpfung" Thrombose+Beinverlust [68]
weil die Ärzte nicht wissen, wie man die
"Coronaimpfung" ausleitet und die Thrombose beseitigt
- sie wollen nicht lernen!
DAS ALLES geschah dank der Impfpropaganda und
Impfhetze der kriminellen Antifa. Die Antifa ist der
Haupttäter beim Coronawahn.
Die Antifa war für die Panikmache in den Medien
(JournalistInnen sind Antifa-Mitglieder), in
Regierungskreisen (Minister und PräsidentInnen sind
Antifa-Mitglieder) UND auf der Strasse mitverantwortlich.
Nur so war es möglich, dass Sperrungen und Lockdowns
verfügt werden konnten:



Der Staatsterror im 4R: Lockdown, Sitzgruppe
eingegittert - 2.3.2021 [104] - Der Staatsterror in
Haltern (4R): Lockdown, Sitzgruppe mit Baum eingegittert
- 2.3.2021 [105] - Staatsterror in Düsseldorf:
Stehenbleiben kostet Geldbusse 2021 [106]
WER ist der Nazi? Die Polizei im Jahr 2021: Abstand
nicht eingehalten!




Staatsterror mit Lockdown in China in Shanghai: Der
Kühlschrank ist leer und man darf nicht einkaufen gehen
- 12.4.2022 [107]
Staatsterror in Basel am 18.10.2021: Besuch der
Herbstmesse ist nur mit "Zertifikat" erlaubt - die
Diktatur der beiden NICHT-Mediziner Berset und Levy
[108]
Staatsterror im 4R mit Abstandsvorschriften im Park -
6.5.2021 [109]
Staatsterror in 4R-Berlin: Die Polizei hält den Abstand
nicht ein - 22.4.2021 [110]



Staatsterror in Dresden: Ein Fahrradfahrer liest aus dem
Grundgesetz vor - die Nazi-Polizei hält den Abstand
nicht ein - 19.4.2021 [111]
Staatsterror in Kempten (4R): Die Polizei agiert gegen
eine Dame mit Hund und hält den Abstand nicht ein
- 17.4.2021 [112]
Staatsterror in Südfrankreich: Die Polizei terrorisiert
Leute am Strand und bedrohen sie mit Maschinengewehren -
6.4.2021 [113]

Staatsterror in Lima (Peru): Präsident Vizcarra lässt
ganze Märkte wochenlang schliessen und die Bevölkerung
hungert, 6.5.2020 [114]
DAS ALLES geschah dank der Impfpropaganda und Impfhetze
der kriminellen Antifa. Wir brauchen diese Arschlöcher
nicht.
ab 2022: Die
Entnazifizierung der Polizei weltweit
Die Polizei wurde erst ab 2022 moderater, weil:
1) weil sie über die kriminelle Antifa aufgeklärt
wurden, wer denn da die Propaganda führt (die jüdische
Antifa wird vom jüdischen Mossad dirigiert, und der
jüdisch-zionistische Mossad ist von der
zionistisch-jüdischen Familie Rothschild in London
direkt geleitet, die Propagandataktik kommt also aus
London)
2) weil nun klar die Notwendigkeit bestand, die
Jugendlichen und die Schulsysteme zu informieren nicht
mehr bei der kriminellen Antifa mitzumachen, denn das
Ziel war, die Jugendlichen zu einem bildungslosen
Proletariat zu "formen" als Grundlage für eine neue
Kommunistische Partei der Schweiz
3) weil die Polizei aufgeklärt wurde, dass die
Regierung GAR KEINE MEDIZINISCHE AUSBILDUNG HATTE
sondern nur auf Befehl "von oben" (Rothschild und
Mossad) handelte, wobei die Familie Rothschild
ebenfalls KEINE medizinische Ausbildung hat, sondern
auch die handeln nur im Sinne der Pharma-Aktien, und
4) weil die geimpften PolizistInnen selber Probleme
bekamen und seit 2022 bei der Polizei Personalmangel
herrscht: Die gesunden UNgeimpften PolizistInnen sind
seit 2022 chronisch überlastet und können und wollen
sich auch keine Konfrontation mit der Bevölkerung mehr
leisten. Sie verweigern die befohlene Aggression.
Weitere kriminelle Aktionen der
kriminellen Mossad-Antifa
-- Verkehrsblockaden mit Begründung "Klimawahn", z.B.
mit einer Greta, mit Inkaufnahme von Blockaden von
Krankenwagen (Todschlag) und Blockade von Flughäfen
(Flug verpasst) - aber Klimawandel gab es immer schon
seit Millionen Jahren, und da gab es noch keine Autos
und keine Motoren...
-- Spionage sowie Erfindung von Delikten für
Strohkopf-Antifa-Regierungen, damit mehr Belohnung
rausspringt (!)
-- Manipulation von E-Mail-Servern mit Blockade von
E-Mails, oder E-Mails landen im Spam-Ordner
-- Infiltration von Telefongesellschaften und
willkürliche Blockade von SMS oder Anrufen - oder
willkürliche Erfindung von Abos
-- Sprayereien an Zügen, S-Bahnen, Güterzügen und
Verkehrsschildern
-- Zerstörung von Verkehrsschildern: Irreführung und Gefährung wird in Kauf
genommen, damit werden auch viele sichere
Parkmöglichkeiten für Fahrräder zerstört
-- Zerstörung von Fahrradabstellplätzen
durch Umbiegen von Haltebügeln
Man sieht, diese kriminelle Antifa sind
Hochkriminelle, sie nehmen jede Gefährdung und auch
Todschlag in Kauf, diese kriminelle Antifa braucht es
NICHT.
Hier sind einige Beispiele aus dem Widerstand, der gegen
die kriminelle Antifa-Lügen und Regierungslügen immer
grösser und stärker wurde:



Widerstand 4R: Der Aluhut hat immer recht, und der
MoSSad ist nun am Arsch [wid 01] - Widerstand gegen
Coronawahn Schweiz: Kleber Impfzwang Nein Danke [wid 02]
- Widerstand "USA" mit Maskenverbrennung 2021 [wid 03]



Wid CH: Graffito: NIE IMPFEN, denn wilde Tiere brauchen
das auch nicht - 2021 [wid 04] - Wid CH: Graffito:
Täglich werden 1 Milliarde Masken verbraucht, 50% davon
landen im Meer - 2021 [wid 05] - Wid CH: Graffito:
Gen-Impfungen sind tödlich - www.med-etc.com - 2021 [wid
06]



Wid CH: Graffito: Bei Grippe / Corona: Es sterben
meistens die Geimpften - 2021 [wid 07] - Wid CH: Platz
der Freiheit - es gilt die Bundesverfassung - 31.7.2021
[wid 08] - Wid CH: Kappe mit "NIE IMPFEN" aufgedruckt -
31.7.2021 [wid 09]
Da gab es in der Schweiz so einen dummen
"Gesundheitsminister" ohne Medizinausbildung Herr
Berset, der gefordert hatte, dass sich UNgeimpfte
Menschen "markieren" sollten - also habe ich mich mit
dieser Kappe "markiert"...



Wid CH: Graffito: Berset+Levy lüegen für den Börsenkurs
- 2021 [wid 10] - Wid CH: Graffito: Diskriminierung ist
verboten, Bundesverfassung Artikel 8, und Naturmedizin
ist erlaubt - 2021 [wid 11] - Wid CH: Graffito: Gegen 1
Grippe braucht es Vitamin C und Zink, aber sicher KEINE
Impfung - 2021 [wid 12]



Wid CH: Graffito: Berset+Levy+Rickli haben KEINE Medizin
studiert, aber haben Aktien. Achtung Falle! 2021 [wid
13]
Wid CH: Jacke mit Aufdruck "NIE IMPFEN - bleiben Sie
gesund - www.med-etc.com" - 2021 [wid 14]
Wid CH: 3G-Regel ist Fascho! Berset+Levy lügen für den
Aktienkurs! - 2021 [wid 15]



Wid CH: 3G-Regel ist Faschismus - 2021 [wid 16] -
Wid CH: 3G-Regel ist Fascho - 2021 [wid
17] - Wid Österreich: Busfahrer schaltet auf "Impfen
ist Mord" [wid 18]



Wid CH: "NIE IMPFEN - bleiben Sie gesund" - 2021 [wid
19] - Wid CH: Graffito: "Die tägliche Impfung gib uns
heute: Zitrone, Grapefruit, Oliven, Kapern,
Pfefferminz, Eukalyptus, Knoblauch, Ingwer. Mahlzeit!"
- Antibiotikapflanzen - 2021 [wid 20] - Wid CH: "Wegen
1 Grippe macht man KEIN THEATER. Du tumme Pundesroot!
- www.med-etc.com" - 2021 [wid 21]



Wid GB: Bestatter John O'Looney
berichtet von Veränderungen bei seinen Beerdigungen -
2022 [wid 22] - Wid CH: Swissair hat gesundes,
UNgeimpftes Personal gekündigt, Piloten und
FlugbegleiterInnen - 2022 [wid 23] - Wid CH: Graffito:
"Die UNgeimpften leben länger" - 2022 [wid 24]




Wid CH im Wallis in Zermatt: Das Restaurant "Walliser
Kanne" verweigerte die Überprüfung von Zertifikaten,
da installierte die Freimaurer-Regierung in Sion eine
Mauer aus Legosteinen [wid 25] - Wid 4R: "Ich denke,
also bin ich Impfverweigerer" - Dezember 2022 [wid 26]
Widerstand mit Demo gegen die kr. WHO mit dem
Pandemievertrag: alles ausleiten und Naturmedizin
einleiten - Oktober 2023 [wid 27]
Widerstand Basel mit Kreide-Graffito: Impfung
ausleiten! - Oktober 2023 [wid 28]




Widerstand mit Demo: "Auf zum Spaziergang!" mit Asterix
und Obelix [wid 29] - Widerstand mit Maske am Ohr, um
sich vor FAKE-News zu schützen - 6.6.2020 [wid 30] -
Widerstand Empfehlung: Vor der "Coronaimpfung" das
Testament schreiben, 6.3.2021 [wid 31] -
Widerstand: Opa mit "Coronaimpfung" wird zur
Risikogruppe, er merkt es nicht - 4.3.2021 [wid
32]




Widerstand mit Warnung: Die Regierung hat KEIN
Medizindiplom - 24.8.2020 [wid 33] -
Widerstand: Die 3-U-Regel für UNgeimpfte: UNgetestet -
UNgeimpft- UNbeugsam - 26.6.2021 [wid 34]
Widerstand mit Warnung am 4.11.2021: 10x impfen in 5
Jahren NEIN! [wid 35]
Widerstand: Die tägliche "Impfung" gib uns heute:
Kartoffelsalat mit Ingwer und Kapern - 5.12.2021 [wid
36]



Widerstand Warnung am 2.12.2021: Wegen einer Grippe
macht man KEIN Theater. Sapperlott! [wid 37] -
Widerstand Warnung: Gegen eine Grippe kann man gar nicht
impfen, weil der Virus immer mutiert - 17.12.2021 [wid
38]
Widerstand Bilanz am 20.3.2023: Die
Verschwörungstheoretiker führen gegen die Lügen der
kriminellen Mossad-Antifa mit 23 zu 0 - sie haben 23mal
recht gehabt [wid 39]
Am Beispiel "Coronawahn" kann man erkennen, WO der
Verstand der kriminellen Antifa und ihrer Mossad-Führer
wirklich ist: bei NULL. Sie gehen in Richtung Selbstmord.
5. Massnahme gegen die kriminelle Antifa
mit LGBTQ an Schulen: Sammelklagen wegen Massenmord an
Trans-Jugendlichen und Total-Verbot der Antifa




Obama fördert Trans (Obama Trans promoter) 2007-2015
[13] - Trump lässt ab 2018 LGBT im Schulsystem zu
(Trump LGBT promoter in school systems 2018) [14]
Biden lässt die LGBT-Doktrin in Schulen weiterlaufen,
Selbstmordrate bei der Trans-Jugend wegen
Unverträglichkeit der Gegenhormone: 41% [15]
Kriminelle Antifa in Therwil (Schweiz) 2022 mit
schwerer Sachbeschädigung durch Sprayen: Das "A" im
Kreis mit der Gender-Doktrin [50]
Die kriminelle Antifa mit LGBTQ erkennen und aus dem
Schulsystem rauswerfen
Eltern und Kinder müssen über dieses Thema "Antifa" ab 10
Jahren informiert werden, und die Eltern bereits, wenn die
Kinder geboren werden. NIEMALS das toxische "T"
akzeptieren.
Und hier ist mein Verdacht, wieso LGBTQ überhaupt
stattfindet: Die Ablenkung von Kriegen
Antifa und die "westlichen" Regierungen werden von der
Rothschild-Familie in London gesteuert, die dort das
Komitee der 300 leitet. Das Komitee der 300 ist die
Körperschaft, wo die Weltereignisse geplant und gesteuert
werden, zusammen mit einem gewissen Luzifer.
Sie
haben KEINE medizinische Ausbildung, sondern
sie kämpfen für eine "Trans-Jugend" - ich meine klar, das
ist ein Ablenkungsmanöver von den Kriegen auf diesem
Planet - also die Leute sollen sich mit diesen
Sex-Trans-Problemen beschäftigen und haben dann keine Zeit
mehr, um über die grossen Massenmord-Verbrechen
nachzudenken: die Kriege.
Rothschild und das Komitee der 300 könnten z.B. so denken:
Oh, da werden einige jugendliche Opfer dann Selbstmord
machen, aber:
-- macht nichts, unsere Pharma-Aktien steigen dabei
-- und die Chirurgendenken: Unsere Gehälter steigen dabei
-- und während Kriegen entwickeln sich immer Organhandel
und Kinderhandel - mit höchsten Kriegsprofiten für die
"Elite"
-- und die Kriege gehen einfach weiter so, und die
Rüstungsaktien steigen einfach weiter so, ohne grossen
Widerstand in den "USA".


Die Chirurgen profitieren von der kriminellen
LGBT-Propaganda an Schulen mit Trans-Operationen an
Jugendlichen (Verstümmelung von Jugendlichen) [30]
Symbol Spritzen: Die kr. Gift-Pharma profitiert vom
Trans-Wahn mit Millionen-Verkäufen von Hormonspritzen
[31]
Also ich meine klar: Das Thema LGBTQ ist eine grosse
Ablenkungstaktik.
Kriminelle Antifa im Schulsystem
Die Antifa ist die Strassenorganisation vom Mossad von
Rothschild - um die Jugend in allen "westlichen" Ländern
zu manipulieren - und seit 2013 ist sie nun auch direkt im
Schulsystem mit LGBT-Zimmern integriert - wo
Trans-Jugendliche mit einer Selbstmordrate von 41%
systematisch in den Selbstmord gejagt werden - dabei wird
vorgelogen, das sei ein "sicherer Ort" ("safe place"):
TOTALE IRREFÜHRUNG:




Die kr. Antifa behauptet, das
Trans-Gender-Zimmer in der Schule sei ein "safe place",
und die LehrerInnen bemerken die Falle nicht! [29]
Die Trans-Jugendlichen vertragen die Gegenhormone nicht
und landen in einer Selbstmordrate von 41%, z.B. an
einem Bahnübergang mit orangen Lichtern [35]
Die kr. Antifa mit Demos für die Trans-Jugend mit der
Antifa-Faust - nimmt 41% Selbstmordrate in Kauf [126]
Demo-Plakat der kr. Antifa mit dem Wort TrAns mit dem A
im Kreis - das klassische Antifa-Symbol [124]
Was die Antifa mit dem "Coronawahn" in der Welt
angerichtet hat mit der Erfindung, UNgeimpfte sollen
"Nazis und Rechtsradikale" sein, das ist mentale
Vergewaltigung der GANZEN Welt.
UND:
Was die Antifa in den Schulsystemen des "Westens" (Europa,
"USA", Kanada, Australien, Neuseeland etc.) mit ihren
geheimen LGBT-Räumlichkeiten anrichtet, ist
MENTALE
VERGEWALTIGUNG der Jugendlichen, die die Sache noch
nicht analysieren können. Ich denke, das ist
der richtige Ausdruck dafür. Und wohin gehören diese
Vergewaltiger? Auf eine Gefängnisinsel, denke ich.

Gefängnisinsel Alcatraz vor San Francisco [122]
Ich empfehle Sammelklagen:
Punkt 1: Sammelklagen gegen die kriminelle Antifa
wegen Massenmord mit LGBT-Propaganda in Schulen bei
41% Selbstmordrate
Es ist klar, dass alle Eltern, die ein Kind durch
Selbstmord während einer Behandlung mit Gegenhormonen oder
nach einer Operation verloren haben - das Recht auf eine
Sammelklage gegen die kriminelle Antifa haben, die der
Organisator der LGBT-Propaganda ist. Sie provozieren damit
einen Massenmord ohne Ende. Das ist ein Massenmord, weil
der Selbstmord erwartet werden kann, wenn die Quote 41%
beträgt (!). Die Antifa-AktivistInnen MÜSSEN DAVON GEWUSST
haben. Denen ist das einfach egal? Dann muss die
Bestrafung noch höher sein. Ist da irgendwo eine
Gefängnisinsel?
Punkt 2: Die kriminelle Antifa-Organisation sofort
schliessen, um weiteren Schaden zu verhindern
Man muss die kriminelle Antifa verbieten, die in Europa
und in anderen Ländern des "Westens" einen immens hohen
Schaden anrichtet, denn
-- sie spalten Familien, und
-- sie spalten die Gesellschaft, und
-- sie wollen neue Sklaven für die Handy-Diktatur mit der
E-Identität (dann kann man den Leuten wie in China den
Pass einfach abschalten, wenn sie "etwas Falsches"
machen).
Punkt 1: Sammelklagen gegen die kriminelle Antifa
Punkt 2: Antifa sofort verbieten. Es muss weltweit eine
Säuberung stattfinden - samt der Rothschild-Familie, die
ins Gefängnis muss.
Es muss also heissen:
Kriminell-kommunistische Antifa gegründet 1942 in Moskau -
verboten wegen Massenmord durch die hohe Selbstmordrate in
der Trans-Jugend 2024 weltweit.
PLUS: Neutralisierung der hochkriminellen Familie
Rothschild und des sogenannten Luzifer.
Fuck You Antifa - und die Rothschilder mit ihrem Luzifer
auch. Sie sollen den Planeten endlich in Ruhe lassen.



Rothschild regiert den Mossad und die Antifa von
London aus. Der Baron Benjamin Rothschild ist kürzlich
gestorben - aber andere Rothschilder sind noch nicht
hinter Gitter! [10] Antifa RAUS! wegen schwerer
Irreführung+Diskriminierung+Massenmord etc. [120]
Antifa muss VERBOTEN werden - wegen schwerer
Irreführung+Diskriminierung+Massenmord etc. [121]




Ehrenburg ohne jede Ehre [2]
Nakba 1948 [3]




Kalergiplan von 1922: Europa mischen und abstürzen lassen [5]